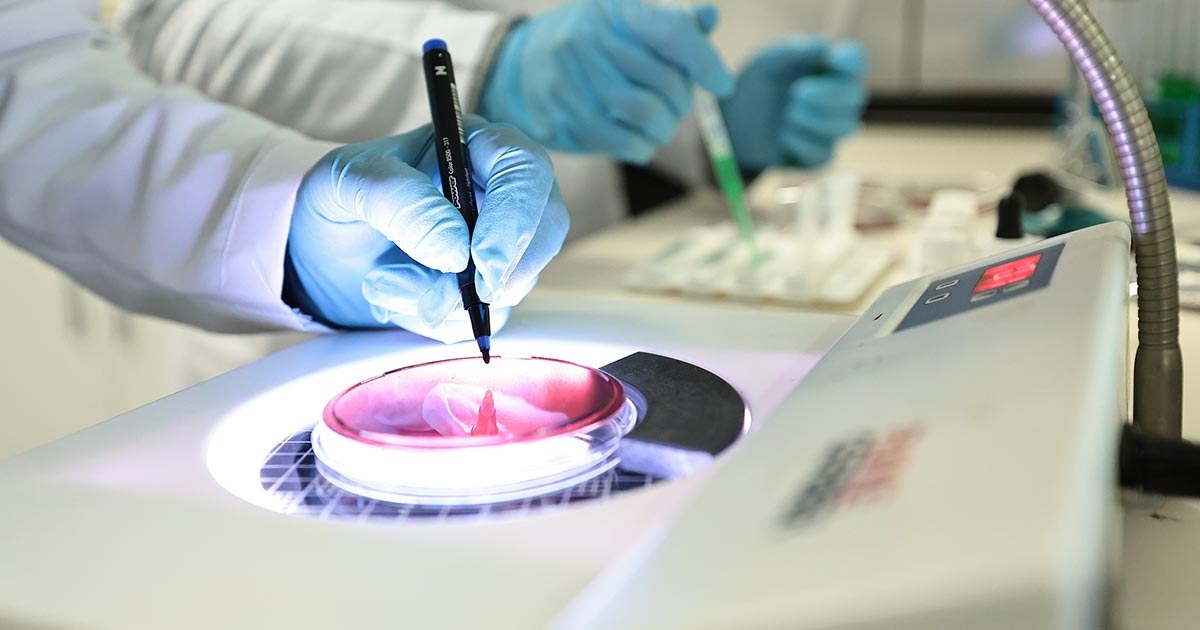

DENÇEV’E TÜRKAK’TAN ULUSLARARASI GEÇERLİLİK ONAYI
Denizli Su ve Kanalizasyon İdaresi (DESKİ) bünyesinde faaliyet gösteren Denizli Çevre Kalite Laboratuvarı (DENÇEV), Türk Akreditasyon Kurumu (TÜRKAK) tarafından gerçekleştirilen denetimleri başarıyla tamamladı. TS EN ISO/IEC 17025 standardı kapsamında akreditasyonunu yenileyen DENÇEV, hizmet kapsamını da genişletti.

Denizli Su ve Kanalizasyon İdaresi (DESKİ) Genel Müdürlüğü’ne bağlı Denizli Çevre Kalite Laboratuvarı (DENÇEV), çevre laboratuvarcılığı alanındaki yetkinliğini bir kez daha tescilledi.
DENÇEV, Türk Akreditasyon Kurumu (TÜRKAK) tarafından yürütülen kapsamlı denetimlerin ardından, TS EN ISO/IEC 17025 standardı çerçevesinde akreditasyon belgesini yeniledi. Ayrıca, hizmet kapsamını genişleterek ulusal ve uluslararası geçerliliğe sahip analiz hizmetlerini sürdürmeye devam edecek.
TÜRKAK uzmanları tarafından titizlikle yürütülen denetim sürecini başarıyla tamamlayan DENÇEV, sunduğu hizmetlerin kalite güvencesini bir kez daha kanıtladı.
BEŞ TEKNİK ALANDA YETKİN HİZMET
Beş farklı teknik alanda faaliyet gösteren DENÇEV; Numune Alma, Numune Kabul ve Raporlama, Mikrobiyoloji, Kimya ve Kömür Servisi birimleriyle çevre analizlerinde hızlı, güvenilir ve tarafsız sonuçlar sunuyor.
Modern laboratuvar altyapısı, güçlü teknolojik donanımı ve bilimsel esaslara dayalı çalışma prensibiyle öne çıkan DENÇEV, Ege Bölgesi’nin ve Türkiye’nin en donanımlı çevre laboratuvarlarından biri olarak gösteriliyor.
Sürekli gelişim vizyonuyla çalışmalarını sürdüren laboratuvar, mevcut hizmetlerinin yanı sıra Ar-Ge odaklı projelerle çevre analizlerinde öncü rolünü güçlendirmeyi hedefliyor.
TÜRKAK akreditasyonu ile birlikte, Çevre, Şehircilik ve İklim Değişikliği Bakanlığı tarafından verilen “Çevre Ölçüm ve Analiz Yeterlik Belgesi”, laboratuvarın bilimsel, güvenilir ve tarafsız hizmet anlayışının bir göstergesi olarak öne çıkıyor.
GENEL MÜDÜR BEŞLİ: TAKIM ÇALIŞMASININ SONUCU
DENÇEV’in denetim sürecini başarıyla tamamlamasının ardından DESKİ Genel Müdürü Egemen Emre Beşli, emeği geçen personele teşekkür etti.
Beşli açıklamasında şunları söyledi:
“Denizli’mizin ve ülkemizin sağlıklı çevre koşullarına ulaşması adına büyük bir sorumluluk üstleniyoruz. DENÇEV’in bu denetim sürecinden başarıyla geçmesinde emeği olan tüm personelimize özverili çalışmaları, teknik bilgi birikimleri ve disiplinli yaklaşımları için teşekkür ediyorum. Başkanımız Bülent Nuri Çavuşoğlu’nun liderliğinde bu başarı, takım çalışmasının, bilimsel anlayışın ve sürekli gelişim vizyonunun bir sonucudur.”





